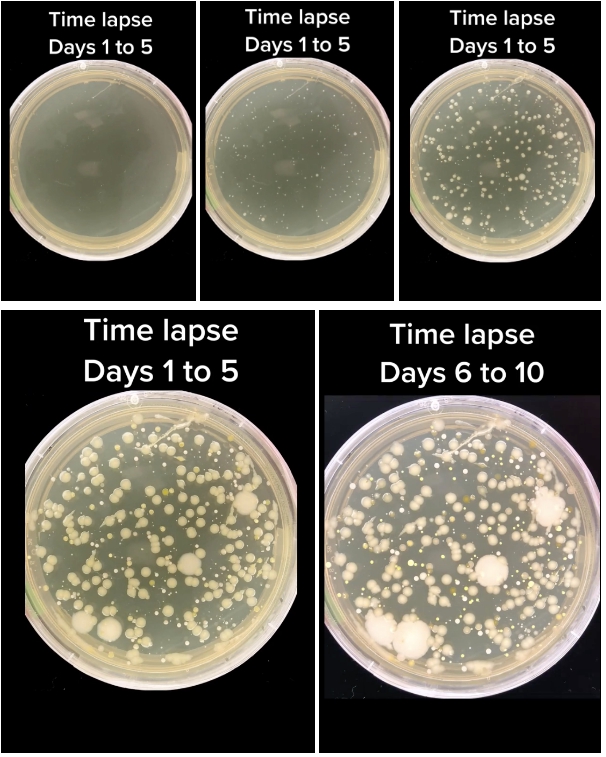

-
 Bão Maysak tăng cấp bất ngờ, chuyển hướng áp sát vùng biển Quảng Ninh - Hưng Yên
Bão Maysak tăng cấp bất ngờ, chuyển hướng áp sát vùng biển Quảng Ninh - Hưng Yên -
 Trứng lòng đào có thực sự bổ hơn trứng chín?
Trứng lòng đào có thực sự bổ hơn trứng chín? -
 Từ 15/8, che biển số ô tô có thể bị phạt đến 26 triệu đồng
Từ 15/8, che biển số ô tô có thể bị phạt đến 26 triệu đồng -
 Video: Khám xét khẩn cấp nhà Tăng Nhật Tuệ liên quan đến đường dây ma túy quy mô
Video: Khám xét khẩn cấp nhà Tăng Nhật Tuệ liên quan đến đường dây ma túy quy mô -
 Những loại trái cây thơm ngon người tiểu đường có thể ăn "thả ga" không lo tăng đường huyết
Những loại trái cây thơm ngon người tiểu đường có thể ăn "thả ga" không lo tăng đường huyết -
 Va chạm kinh hoàng với xe khách rạng sáng, hai người nghi trộm chó tử vong tại chỗ
Va chạm kinh hoàng với xe khách rạng sáng, hai người nghi trộm chó tử vong tại chỗ -
 PNJ lên tiếng khẳng định chất lượng kim cương, sẵn sàng cho khách hàng truy xuất nguồn gốc
PNJ lên tiếng khẳng định chất lượng kim cương, sẵn sàng cho khách hàng truy xuất nguồn gốc -
 Người đàn ông chở 4 cô gái "làm xiếc" trên đường vi phạm nhiều lỗi, hé lộ số tiền phạt phải đóng
Người đàn ông chở 4 cô gái "làm xiếc" trên đường vi phạm nhiều lỗi, hé lộ số tiền phạt phải đóng -
 Giật mình thói quen giữ lại nước lẩu qua đêm: Đun sôi 2 tiếng cũng không hết độc tố
Giật mình thói quen giữ lại nước lẩu qua đêm: Đun sôi 2 tiếng cũng không hết độc tố -
 Nhiều hộ dân ở TP HCM có nhà, có sổ đỏ nhưng hơn 10 năm không thể về ở vì bị "mất lối đi"
Nhiều hộ dân ở TP HCM có nhà, có sổ đỏ nhưng hơn 10 năm không thể về ở vì bị "mất lối đi"
Lối Sống
04/09/2023 17:00Vật dụng quen thuộc trong bếp chứa 'ổ vi khuẩn' mà xà phòng và nước nóng cũng không thể tiêu diệt hết
Căn bếp thường được coi là trái tim của cả ngôi nhà, nơi tạo ra những món ăn ngon, đầy đủ dinh dưỡng, và với nhiều gia đình đây còn là không gian sinh hoạt gắn kết các thành viên. Vì vậy việc giữ gìn vệ sinh sạch sẽ khu vực bếp của mỗi gia đình luôn là việc cần được ưu tiên.
Tuy nhiên, dù vệ sinh thường xuyên nhưng ít ai để ý đến việc làm sạch bồn rửa và miếng giẻ rửa bát. Trong khi nhiều thí nghiệm cũng như nghiên cứu từ các chuyên gia đã chỉ ra, đây là những thứ chứa nhiều vi khuẩn nhất trong bếp.

Các nhà nghiên cứu tại Đại học Reading (Anh) đã phát hiện bồn rửa trong bếp, đặc biệt là lỗ thoát nước có chứa 605 loài nấm sinh sôi nảy nở và hàng triệu vi khuẩn gây bệnh.
Theo công bố trên tạp chí Environmental DNA của nhóm nghiên cứu này, họ tìm thấy trong 400 mẫu thử tại các bồn rửa của gia đình các loại nấm tạo ra độc tố mạnh, gây bệnh nhiễm trùng nghiêm trọng, đặc biệt là ở những người suy giảm hệ miễn dịch. Ngoài ra còn có các loại nấm men đen gây viêm phổi và các bệnh truyền nhiễm mãn tính hay lang ben.
Tiến sĩ Charles Gerba, Nhà Vi trùng học, giáo sư Đại học Arizona (Mỹ) cho biết: "Bồn rửa nhà bếp là nơi chứa đầy vi trùng. Thử nghĩ mà xem, bạn đổ mọi thứ vào nó. Bạn thái thịt sống sau đó rửa sạch thớt trong bồn rửa. Bạn đổ đồ ăn thừa vào bồn rửa. Bạn rã đông các loại thịt đông lạnh hoặc rửa gà sống. Đó là lý do vì sao có nhiều vi khuẩn trong bồn rửa hơn cả trong bồn cầu".


Ngoài thực phẩm thì miếng giẻ rửa bát cũng có thể là nguyên nhân gây nhiễm khuẩn cho bồn rửa. Miếng giẻ rửa bát nhỏ bé quen thuộc trong nhà bếp thậm chí còn bẩn gấp 200.000 lần bồn cầu. Trên miếng rửa bát bằng mút có đến 10 triệu vi khuẩn trên mỗi 2,54cm vuông và 1 triệu con nếu miếng giẻ bằng vải.
Khi người sử dụng dùng những miếng giẻ rửa bát đầy vi khuẩn này để lau chùi bồn rửa, chúng có thể lây nhiễm chéo vi khuẩn Campylobacter jejuni, Salmonella và Ecoli cho bồn rửa và các vật dụng xung quanh. Loại vi khuẩn này khi xâm nhập vào cơ thể người có thể gây nôn mửa, tiêu chảy, sốt và các biểu hiện ngộ độc thực phẩm khác.

Thói quen làm sạch bồn rửa của các gia đình là cọ sạch với xà phòng (thường là nước rửa chén), sau đó đổ nước sôi tráng lại lần nữa và yên tâm rằng “quy trình diệt khuẩn” này hiệu quả. Tuy nhiên, có một sự thật rằng, nước nóng hay chất tẩy rửa thông thường cũng không đủ để tiêu diệt các loại nấm sống trong bồn rửa. Video của tài khoản mạng xã hội What Might Grow sau đây sẽ khiến nhiều người rùng mình.
Tác giả đã tiến hành thí nghiệm bằng 2 cách. Cách thứ nhất là cho đồ ăn vào bồn rửa, sau đó rửa sạch bằng nước thường. Sau khi lấy mẫu nước trong bồn và soi dưới kính hiển vi đã phát hiện ra một lượng vi khuẩn lớn.
Ở cách thứ hai, người này đã dùng xà phòng kỳ cọ bồn rửa thật kỹ, cuối cùng dùng nước nóng rửa sạch lại và lấy mẫu nước trong bồn để soi dưới kính hiển vi. Kết quả cho thấy, ngày đầu tiên phần nước này không hề có dấu hiệu của vi khuẩn. Tuy nhiên, vi khuẩn dần xuất hiện ở những ngày tiếp theo và sinh sôi với tốc độ chóng mặt. Ước tính trong vòng 10 ngày, chỉ từ 20 con đã sinh sôi lên đến số lượng 45.000 con vi khuẩn.
Thử nghiệm chứng minh việc tiêu diệt vi khuẩn và nấm mốc trong bồn rửa bằng nước sôi và xà phòng không hiệu quả (Video What Might Grow)
Nguyên nhân là do các loại nấm này có thể chịu được nhiệt độ cao, độ pH axit và thậm chí có thể sinh sôi trong môi trường thiếu dinh dưỡng. Nên việc tiêu diệt chúng không hề dễ dàng.
Theo PGS.TS Nguyễn Duy Thịnh (nguyên giảng viên Viện Công nghệ thực phẩm, trường Đại học Bách Khoa, Hà Nội), tuy rằng quá trình cọ rửa có thể tiêu diệt một phần vi khuẩn nhưng chưa chắc đã tiêu diệt được toàn bộ. Hơn nữa, vi khuẩn trong bồn có thể xuất hiện trở lại do dụng cụ cọ rửa không sạch, hoặc vi khuẩn lây lan từ ống rác...
Vệ sinh bồn rửa như thế nào cho đúng?
Như đã nói ở trên, vi khuẩn và nấm mốc sinh sôi ở bồn rửa tiềm ẩn rất nhiều nguy cơ cho sức khỏe nếu chúng xâm nhập vào cơ thể người. Nên các chuyên gia khuyến cáo cần vệ sinh bồn rửa hàng ngày, tránh tình trạng lây nhiễm chéo vi khuẩn sang thực phẩm và những đồ dùng xung quanh.
Khi vệ sinh bồn rửa, các gia đình nên sử dụng sản phẩm tẩy rửa chuyên dụng. Tuy nhiên, để thân thiện với môi trường hơn, cũng có thể sử dụng hỗn hợp baking soda và giấm; hoặc dùng muối và chanh; hay dùng bộ ba muối, giấm và nước nóng để làm sạch. Đây đều là những chất tẩy rửa thiên nhiên, có độ an toàn cao, hiệu quả tốt.

Bước đầu tiên cần làm trước khi vệ sinh bồn rửa là đổ sạch rác trong rổ chứa rác của bồn, kể cả những vụn rác nhỏ bám xung quanh. Sau đó dùng bàn chải cọ rửa sạch cặn bẩn bám trên rổ rác.
Bộ phận cần được làm sạch tiếp theo là vòi nước. Hàng ngày số lần các thành viên trong gia đình chạm tay vào vòi nước cũng rất nhiều nên các gia đình cần lưu ý không được bỏ qua khu vực này.
Tiếp đến phần quan trọng và tốn nhiều công sức nhất là cọ rửa bồn và thành bồn rửa bát. Nên sử dụng thêm miếng bọt biển hoặc miếng rửa bát làm từ sợi ráp để cọ rửa hiệu quả hơn. Đừng quên cọ những ngóc ngách nhỏ thật kỹ để vết bẩn biến mất.

Cuối cùng, sau khi đã cọ sạch tất cả, hãy đổ nước sôi 100 độ C vào rổ lọc rác và toàn bộ bồn rửa. Việc này vừa giúp khử khuẩn, vừa giảm tình trạng tắc cống, ngăn mùi hôi để căn bếp của gia đình luôn sạch bong, sáng bóng. Và thường xuyên thay, giặt giẻ rửa bát, phơi khô dưới ánh nắng để tránh vi khuẩn, nấm mốc sinh sôi.
Theo Thiên An (Phụ Nữ Số)








- Thắng dễ Algeria, Thụy Sĩ vào vòng 1/8 World Cup (52 phút trước)
- Bão Maysak tăng cấp bất ngờ, chuyển hướng áp sát vùng biển Quảng Ninh - Hưng Yên (1 giờ trước)
- Ông Trump mua loạt cổ phiếu công nghệ ngay trước quyết định hoãn áp thuế, danh mục đầu tư gây chú ý (1 giờ trước)
- Thành viên Da LAB "đốn tim" người hâm mộ với visual thần tượng tại tập 1 Anh trai vượt ngàn chông gai 2026 (1 giờ trước)
- Trứng lòng đào có thực sự bổ hơn trứng chín? (1 giờ trước)
- Mỹ chôn hộp thời gian thép nặng 400 kg kỷ niệm 250 năm quốc khánh (1 giờ trước)
- Vụ Cựu cán bộ Cục Thuế Đắk Lắk bị bắn 5 phát súng tử vong: Hàng xóm tiết lộ thông tin gây ngỡ ngàng (1 giờ trước)
- Chiếc áo da có chữ ký tươi của CEO Nvidia Jensen Huang được đưa lên sàn đấu giá, dự kiến chạm mốc hàng tỷ đồng (2 giờ trước)
- Bom tấn "The Odyssey" của Christopher Nolan khuấy đảo toàn cầu trước ngày công chiếu (2 giờ trước)
- "Cơn khát" xăng dầu bủa vây nước Nga sau loạt đòn tập kích hạ tầng (2 giờ trước)
Bài đọc nhiều















